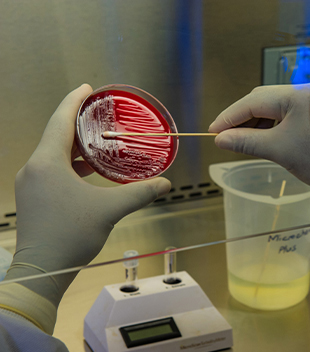

2025년 상반기, 투자자들의 이목을 집중시킨 가장 핫한 이슈는 단연 인투셀 공모주 청약이었습니다. 높은 경쟁률과 글로벌 기술력을 기반으로 한 인투셀은 상장 전부터 기대를 한몸에 받으며 수요예측과 청약 과정에서 놀라운 기록을 세웠습니다. 지금부터 인투셀 공모주 청약과 관련된 핵심 정보를 총정리해보겠습니다. 청약전 투자설명서는 반드시 확인하세요. ↓ ↓ ↓ ↓ ↓ ↓ ↓ ↓ 아래 링크에서 확인가능


1. 인투셀 공모주
인투셀 공모주 청약은 바이오 신약 플랫폼 기술을 보유한 유망 기업 ‘인투셀’이 진행한 첫 상장 공모였습니다. 인투셀은 항체-약물 접합체(ADC) 플랫폼 기술인 ‘오파스(OHPAS)’를 자체 개발한 기업으로, 글로벌 제약사들과 기술이전 가능성을 높이고 있습니다. 이런 기술력을 기반으로 인투셀 공모주 청약은 상장 전부터 대규모 관심을 끌었으며, 일반 투자자 및 기관투자자들의 자금이 대거 몰리게 된 결정적인 계기가 되었습니다. 이미 다수의 투자자들이 ‘인생 공모주’라 부를 정도로, 인투셀 공모주 청약은 고수익을 노리는 투자자라면 반드시 주목해야 할 대형 이벤트였습니다.



2. 인투셀 수요예측결과
인투셀 공모주 청약의 수요예측 결과는 기대 이상이었습니다. 2025년 4월 29일부터 5월 8일까지 진행된 기관투자자 대상 수요예측에는 총 2,391개 기관이 참여했으며, 경쟁률은 무려 1,151.5대 1을 기록했습니다. 이는 최근 몇 년간 진행된 바이오 기업 공모 중에서도 손꼽히는 수치로, 인투셀 공모주 청약에 대한 시장의 기대감이 얼마나 컸는지를 반증합니다. 희망공모가 밴드 상단인 17,000원으로 확정된 공모가는, 시장이 인투셀의 기술력과 성장 가능성을 적극 반영한 결과라 할 수 있습니다.
3. 인투셀 상장
인투셀 공모주 청약을 통해 상장을 준비한 인투셀은 오는 5월 23일 코스닥 시장에 공식 상장할 예정입니다. 상장일 기준 시가총액은 약 2,521억원으로 예상되며, 상장 직후 주가 급등 가능성도 점쳐지고 있습니다. ‘따상(공모가의 2배 시초가 + 상한가)’ 달성 여부에 대해 많은 투자자들이 주목하고 있으며, 인투셀 공모주 청약을 통해 배정받은 투자자들의 단기 수익 실현 여부에도 큰 관심이 쏠려 있습니다. 인투셀의 기술력과 시장 평가가 맞물릴 경우, 상장 당일 ‘급등 이벤트’가 펼쳐질 가능성이 매우 높습니다.

4. 인투셀 수요예측
기관 수요예측에서는 인투셀의 ADC 플랫폼이 기존 글로벌 경쟁사 대비 독보적인 성능을 보인다는 점이 긍정적으로 평가되었습니다. ‘콘쥬올(ConjuALL)’과 ‘오파스(OHPAS)’ 플랫폼은 기술이전 가능성뿐 아니라 글로벌 신약 시장 진입에 있어서도 매우 강력한 무기가 될 수 있습니다. 이러한 기대감은 수요예측에 직접적인 영향을 미쳤고, 인투셀 공모주 청약 과정에서 희망공모가 상단 확정이라는 결과로 이어졌습니다. 수요예측의 결과는 청약 전략 수립에도 큰 힌트를 주는 만큼, 향후 공모주 투자 시 참고자료로 삼을 가치가 충분합니다.
5. 인투셀 균등
균등 방식은 최근 공모주 투자에서 일반 투자자들이 가장 선호하는 배정 방식입니다. 인투셀 공모주 청약에서도 균등 배정 물량이 포함되어 있어, 소액 투자자도 청약에 참여만 하면 일정 수량을 배정받을 수 있는 기회가 열렸습니다. 실제로 20주 청약 시 증거금 17만 원만 있으면 균등배정을 받을 수 있었기 때문에, 접근성이 매우 높았습니다. 인투셀 공모주 청약은 균등+비례 병행 방식으로 진행되어 투자 전략에 따라 청약 방식 조절이 가능했으며, 이는 투자자 만족도 상승에도 크게 기여했습니다.



6. 인투셀 공모주배정
‘인투셀 공모주 청약’에 참여한 투자자들은 공모가 기준으로 배정 수량에 따라 수익을 예측할 수 있습니다. 비례 배정에서는 청약 수량과 경쟁률을 계산해 주식을 배정받게 되며, 이번 인투셀의 경우 비례 경쟁률이 무려 4537.7대 1이었습니다. 이는 배정 수량이 매우 적을 수 있다는 의미이기도 하지만, 반대로 상장 이후 주가 상승 시 그만큼 높은 수익률을 기대할 수 있는 구조입니다. ‘인투셀 공모주 청약’에서 균등과 비례의 전략적 활용은 배정 물량 확보에 결정적인 요인이었습니다.
7. 인투셀 청약계산기
‘인투셀 공모주 청약’에 참여하기 전, 자신의 예상 배정 주식 수를 계산하고자 하는 투자자라면 ‘청약계산기’ 활용이 필수입니다. 미래에셋증권, 네이버 주식 정보, 카페 등에서는 간편하게 입력만 하면 배정 수량과 경쟁률을 바탕으로 예상 수익까지 시뮬레이션 해주는 도구들이 제공됩니다. ‘인투셀 공모주 청약’ 계산기를 사용하면, 증거금 대비 수익률, 배정 가능성, 단기·장기 보유 전략 수립까지 손쉽게 확인할 수 있어 청약 전략에 큰 도움이 됩니다.
8. 청약 전 확인서류(필수)
인투셀 공모주 청약전 반드시 확인해야할 서류가 있습니다. 공모주마다 투자설명서와 증권관련서류가 있습니다. 공모주 청약전 유의사항을 반드시 읽고 숙지후 청약신청하시기 바랍니다.
결론: 인투셀 공모주 청약은 2025년 공모주 투자의 기준
‘인투셀 공모주 청약’은 높은 수요예측 경쟁률, 균등+비례 전략, 기술 기반 플랫폼 등 투자자가 선호할 수 있는 요소를 모두 갖춘 종합 공모주였습니다. 공모주 투자를 고려하는 사람이라면 인투셀 공모주 청약 사례를 반드시 복기해야 합니다. 실수 없는 청약을 위해 위 정보를 꼭 체크하고, 앞으로 있을 추가 기술이전 뉴스나 주가 흐름도 예의주시해야 수익 기회를 놓치지 않을 수 있습니다.
다음 추천글
인투셀 공모주 청약 경쟁률 4537대1! 일반청약 방법과 수익전망 총정리
2025년 5월, 인투셀의 공모주 청약이 투자자들 사이에서 큰 화제를 모았습니다. 특히 일반청약 경쟁률이 4537.7대 1에 달하며, 공모주 시장의 뜨거운 관심을 입증했습니다. 이번 글에서는 인투셀 공
kingdom2025.com
코인베이스 글로벌 주가 총정리 (+기술적분석)
코인베이스 글로벌(COIN)은 미국 최대의 암호화폐 거래소로, 최근 주가가 상승세를 보이며 투자자들의 관심을 끌고 있습니다. 이번 포스팅에서는 코인베이스 글로벌의 회사 개요부터 시황 분석,
kingdom2025.com
KODEX 200선물인버스2X 주가 전망 기술적분석 총정리(+수익필독)
요즘 같은 변동성 장세에서 KODEX 200선물인버스2X에 관심이 쏠리고 있습니다. 이 상품은 코스피200지수의 하락에 베팅할 수 있는 대표적인 2배 인버스 ETF로, 단기 수익을 노리는 투자자들에게 주목
kingdom2025.com
로킷헬스케어 공모주 주가 수요예측결과 총정리 (+기술적분석)
최근 공모주에 대한 인기가 급상승하고 있습니다. 투자자들이 관심을 가지는 이유는 단 한가지 입니다. 수익이 나기 때문입니다. 오늘 로킷헬스케어 상장일인데 79%까지 급상승하였습니다. 로킷
kingdom2025.com










